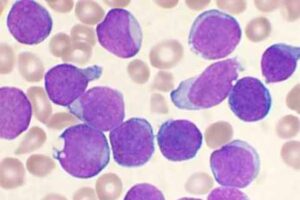

Um estudo recente publicado na revista científica Nature Communications revelou que diferentes tipos de células, até mesmo as cancerígenas, tem um padrão único de enzimas metabólicas dentro do núcleo, e que interagem com o DNA. A pesquisa sinaliza para ciência possíveis novos caminhos para combater o câncer.
Os pesquisadores identificaram mais de 200 enzimas metabólicas, boa parte delas responsáveis pela produção de energia nas mitocôndrias, sobre o DNA humano. Essa é a primeira evidência de que as células humanas têm o que os pesquisadores chamam de “impressão digital nuclear”.
Mesmo que ainda sejam necessários outros estudos para entender melhor as enzimas, e se elas estão catalisando reações, ativando ou desativando genes ou até fornecendo suporte estrutural. Ainda assim, a pesquisa oferece novas pistas sobre como os diferentes tipos de tumores crescem, se adaptam e resistem ao tratamento.
De acordo com os pesquisadores, muitas dessas enzimas sintetizam componentes essenciais à vida, e a localização nuclear delas, está associada ao reparo do DNA. A equipe realizou a descoberta utilizando um método que isola fisicamente as proteínas ligadas à cromatina, estado natural do DNA nas células humanas.
“A presença no núcleo pode, portanto, influenciar diretamente a forma como as células cancerígenas respondem ao estresse genotóxico, uma característica de muitos tratamentos quimioterápicos. É um mundo totalmente novo para explorar”, afirmou Sara Sdelci, principal autora do estudo e pesquisadora do Centro de Regulação Genômica, no artigo da Nature Communications.
Os pesquisadores também estudaram outras 44 linhagens de células cancerígenas e 10 de células saudáveis de 10 tecidos diferentes. Tradicionalmente, a ciência acredita que o metabolismo e a regulação do genoma sejam sistemas conectados ocasionalmente, na maioria das vezes separados. O que acontece é que o núcleo abriga o genoma enquanto as enzimas metabólicas geram energia para as células nas mitocôndrias e no citoplasma.
Quando o estudo revelou que as enzimas metabólicas parecem ser participantes ativas na biologia nuclear, os pesquisadores tiveram uma grande surpresa. Eles puderam ver que 7% de todas as proteínas encontradas ligadas à cromatina eram enzimas metabólicas, o que mostra que o núcleo das células tem o próprio “mini metabolismo independente”.
O número de enzimas pode variar de acordo com o tipo do câncer, nas células de câncer de mama, por exemplo, enzimas de fosforilação oxidativa são comuns, mas ausentes nas células de câncer de pulmão. Ainda assim, o que os pesquisadores observaram foi um padrão semelhante entre os tecidos analisados, que demonstraram uma natureza específica da doença no metabolismo nuclear.
A descoberta traz novas questões aos estudos e debates sobre o funcionamento dos tratamentos contra os diferentes tipos de câncer. De acordo com os autores do estudo, a nova pesquisa é a primeira evidência global de que o núcleo está repleto de enzimas metabólicas. Para eles, mapear a localização e a função dessas enzimas a longo prazo poderá ajudar a identificar novos diagnósticos e vulnerabilidades que medicamentos anticancerígenos podem explorar.